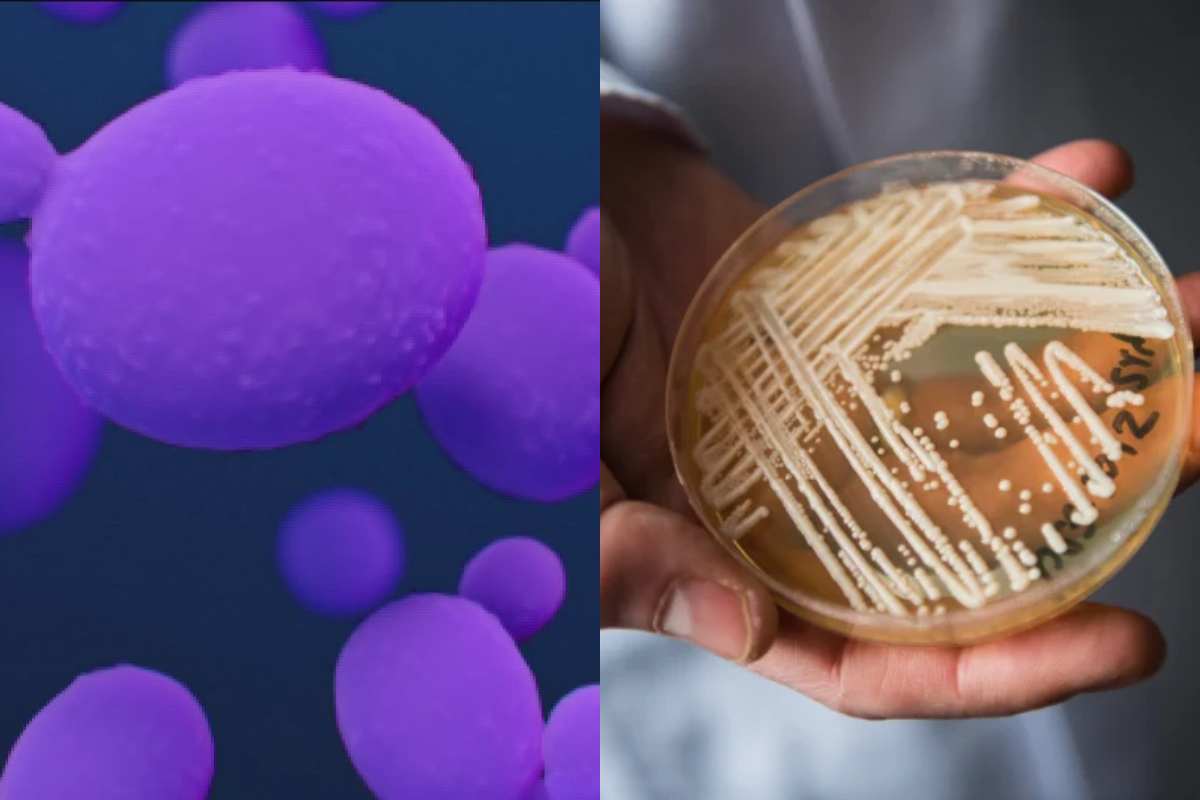

A reporter mistakenly opens the USB letter bomb in the newsroom
Explosive devices received through the mail have been directed at journalists throughout...
CDC claims that fungal infections are spreading all over the US at an ‘alarming’ rate
According to the Centers for Disease Control and Prevention, a lethal fungal illness that is difficult to treat is growing at an “alarming” rate (CDC).
According to the CDC study, US cases nearly doubled in 2021, rising from 756 to 1,471.
Candida auris does not affect healthy people, but it can cause serious sickness or death in those with weakened immune systems or in those who use medical devices like ventilators or catheters. The vast majority of tested patients were resistant to anti-fungal therapy.
The CDC has referred to it as an “urgent antimicrobial resistance threat” as a result. Hospitals and senior living facilities are filled with patients.
According to CDC epidemiologist Dr. Meghan Lyman, the report’s primary author, one in three patients with invasive infections pass away. Nevertheless, it can be challenging to determine exactly what role Candida auris played in particularly susceptible patients.
Infection was initially identified in the US in 2016. According to CDC data that was published in the Annals of Internal Medicine, the most pronounced increase in cases occurred between 2020 and 2021.
The rise in instances that were “resistant to echinocandins,” the antifungal drug most frequently suggested for the treatment of the infection, was another cause for concern.
The CDC blames increased screening efforts and subpar infection control in healthcare settings for the spike.
It might have been worse as a result of the Covid-19 pandemic’s burden on the healthcare and public health systems.
According to Dr. Lyman, the increase “emphasizes the need for ongoing surveillance, more lab capacity, quicker diagnostic tests, and adherence to proven infection prevention and management,” according to CBS News.
Cases of Candida auris have been rising in other nations as well. The World Health Organization listed it as one of the “fungal priority pathogens” last year.
Catch all the Business News, Breaking News Event and Latest News Updates on The BOL News
Download The BOL News App to get the Daily News Update & Live News.